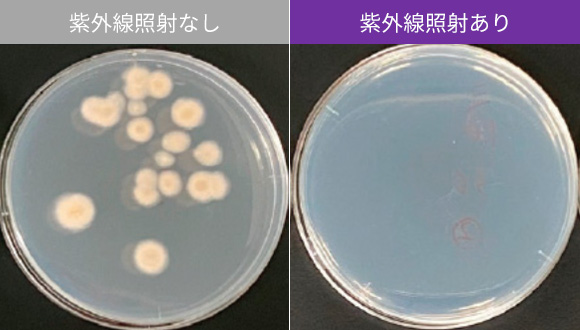
未処理と処理の比較(シャーレ上のカビの繁殖の画像)

![]() 商品紹介 車載用光源・UVシステム・産業用デバイス UV関連製品 紫外線照射装置
商品紹介 車載用光源・UVシステム・産業用デバイス UV関連製品 紫外線照射装置
青果物の腐敗を抑制
廃棄ロス低減、収益アップを加速させます

車載用光源・UVシステム・産業用デバイス
商品ラインアップ
商品情報検索

※紫外線照射装置イメージ
鮮度維持技術
紫外線照射装置
せっかく育てた青果物
鮮度をしっかり維持できれば出荷前や客先でロスにならないのに…

農作物の腐敗を防ぐため農薬や防腐剤を使っているが薬剤はなるべく減らしたい


青果物の腐敗要因の1つであるカビ。
紫外線の除菌効果により表面のカビを抑制することで腐敗を抑制、保存期間を延長します。
紫外線照射による
みかんの腐敗抑制結果

(14日保管後の状態を観測)
柑橘の場合(一例)

主に、青果物等の選果工程等において機器を設置。
青果物の表面に紫外線を照射し、腐敗の原因となる表面のカビ菌を抑制することで、鮮度の持続をサポートします。

※紫外線照射装置仕組みイメージ



 どうして、紫外線で柑橘の鮮度を維持できるの?
どうして、紫外線で柑橘の鮮度を維持できるの?
柑橘の腐敗原因の一つであるカビ菌にも効果を発揮
表面のカビを除菌し腐敗を抑制します
みかん由来カビへの紫外線による抑制効果
(Penicillium digitatumの一例)
(25℃、3日保管後、分析)

紫外線照射により柑橘の果皮にある
強い抗菌物質スコパロンが増加
腐敗を抑制します
| 試験条件 | 試験結果 |
|---|---|
|
温州みかん
|
 |
|
いちご
|
 |
|
ミニトマト
|
 |
【試験機関】当社
※上記試験結果はあくまでも一例です。
※紫外線照射日を0日目としています。
※果実の種類だけでなく、品種やコンディション、天候などの外的要因によっても抑制効果は変化します。
紫外線がウイルスや細菌に照射されると、内部のDNA(デオキシリボ核酸)やRNA(リボ核酸)で吸収され損傷を与えます。これにより複製や増殖を抑え、ウイルスや細菌の活動は抑制されます。






薬剤利用の低減が期待でき、
かつ風味への影響が小さい手法です。


